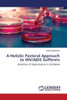

LAP Lambert Academic Publishing
A Holistic Pastoral Approach to HIV/AIDS Sufferers
Product Code:
9783659520785
ISBN13:
9783659520785
Condition:
New
$106.81
$102.80
Sale 4%
A Holistic Pastoral Approach to HIV/AIDS Sufferers
$106.81
$102.80
Sale 4%
Reduction of stigmatisation through a Justice Model, aimed at focusing on A Holistic Pastoral Approach to Sufferers of HIV/AIDS in Zimbabwe. The writer came up with an approach that described a Justice Model summarised in three bold letters RAW that is, Recognition, Acknowledgement and Welcome. The approach inherent in this model and framework can make a vital contribution to reduce stigma and restore heath and dignity of the person in community. Justice implies the notion of equality, solidarity, option for the poor and service to the community for the common good. Poverty has been seed as the main contributory aspect that leads to stigmatisation. It is a method that is rooted in enabling people to resort their dignity and to respect each person as a child of God who is full of compassion. The Justice model is comprised of three main stages in its process: 1. Approach: reaching out, recognising, 2. Accomplishment: to engage, connect empathy and 3. Announcement: empowering, self-esteem. The justice approach is a direct way of Touching People's Lives for development. This model has led the writer to establish a charity called AGAPE Leona Charity to give dignity and life.
| Author: Nyadombo Annah |
| Publisher: LAP Lambert Academic Publishing |
| Publication Date: May 19, 2014 |
| Number of Pages: 452 pages |
| Binding: Paperback or Softback |
| ISBN-10: 3659520780 |
| ISBN-13: 9783659520785 |




